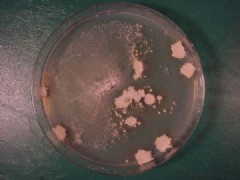
咪康唑軟膏

簡介
 咪康唑軟膏
咪康唑軟膏藥品鑑別
 咪康唑軟膏
咪康唑軟膏含量測定
照高效液相色譜法(附錄ⅤD)測定。色譜條件與系統適用性試驗用十八烷基矽烷鍵合矽膠為填充劑;0.5%醋酸銨溶液-乙腈和甲醇(1:1)混合液(15:85)為流動相;檢測波長為230nm。硝酸咪康唑峰與內標物質峰的分離度應符合要求。內標溶液的製備取鄰苯二甲酸二丁酯適量,加甲醇-氯仿(1:1)製成每1ml中含1.6mg的溶液,搖勻,即得。測定法取本品約2.5g,精密稱定,置50ml量瓶中,精密加內標溶液25ml,加甲醇-氯仿(1:1)稀釋至刻度,搖勻,濾過,取續濾液10μl注入液相色譜儀,記錄色譜圖;另取硝酸咪康唑對照品50mg,精密稱定,置50ml量瓶中,精密加內標溶液25ml,加甲醇-氯仿(1:1)稀釋至刻度,搖勻,同法測定。按內標法以峰面積計算供試品中C18H14Cl4N2O.HNO3的含量。
藥理作用
 酵母菌
酵母菌適應症
皮真菌
皮真菌2.由酵母菌(如念珠菌等)和革蘭陽性細菌引起的陰道感染和繼發感染。
用法用量
 皮膚感染
皮膚感染2.指(趾)甲感染儘量剪盡患甲,每日一次,敷少許藥膏於患處,用手指塗勻。患甲鬆動後(約需2-3周)應繼續用藥至新甲開始生長,確見療效一般需7個月左右。
3.念珠菌陰道炎每日就寢前用塗藥器將藥膏(約5g)擠入陰道深處,必須連續用2周。月經期內也可進行。二次復發後再用,仍然有效。
注意事項
1.避免接觸眼睛和其他黏膜(如口、鼻等)。2.孕婦及哺乳期婦女慎用。
3治療念珠菌病,需避免密封包紮,否則可促使致病菌生長。
4用藥部位如有燒灼感、紅腫等情況應停藥,並將局部藥物洗淨,必要時向醫師諮詢。
5.用於婦科疾病時:無性生活史的女性應在醫師指導下使用;用藥期間注意個人衛生,防止重複感染。
6.對本品過敏者禁用,過敏體質者慎用。
7.本品性狀發生改變時禁止使用。
8.請將本品放在兒童不能接觸的地方。
9.兒童必須在成人監護下使用。
10.如正在使用其他藥品,使用本品前請諮詢醫師或藥師。
衍生膠囊
藥理毒理 三醯甘油
三醯甘油動力學
 腦脊液
腦脊液用法用量
飯後口服。成人一次0.25~0.5g,一日0.5~1g。小兒口服初始劑量為每日30~60mg/kg,而後減為每日10~20mg/kg;嬰兒每日30mg/kg,分2次給藥。療程視病情而定。
不良反應
1.消化道反應如噁心、嘔吐、腹瀉和食慾減退;2.少數患者可發生皮膚瘙癢、皮疹、頭暈、發冷、發熱等,偶可發生過敏性休克;3.偶可發生正常紅細胞性貧血、粒細胞和血小板減少、高脂血症(如膽固醇和三醯甘油的升高)。偶可致血清氨基轉移酶一過性輕度升高。
孕婦及哺乳期婦女用藥:動物試驗顯示咪康唑對胎兒有毒性,因此孕婦禁用本品;本品是否會分泌進入乳汁尚不明確,因此不推薦哺乳期婦女使用本品。
兒童用藥:由於兒童處在生長發育期,肝功能還不完善,用藥量應酌減。
老年患者用藥:對肝功能出現減退的老年患者,用藥量應酌減。
藥物相互作用:1.本品與香豆素或茚滿二酮衍生物等抗凝藥合用時,可增強此類藥物的作用,導致凝血酶原時間延長,對患者應嚴密觀察,監測凝血酶原時間,調整抗凝藥的劑量。2.本品可使環孢素的血藥濃度增高,並可能使腎毒性發生的危險性增加,當兩藥合用時,應對環孢素的血藥濃度進行監測。3.利福平可增強本品的代謝,增加肝臟毒性,合用時可降低本品的血藥濃度,導致治療失敗。與異煙肼合用時亦可降低本品的血藥濃度,故應謹慎合用上述藥物。4.苯妥英鈉與本品合用可引起兩種藥物代謝的改變,並使本品的達峰時間延遲,兩藥合用時應嚴密觀察其反應。5.本品與降糖藥合用時,可由於抑制後者的代謝而致嚴重低血糖症。6.本品與西沙必利合用屬禁忌,因合用時抑制細胞色素P-450代謝通道,可導致心律紊亂。7.本品若與阿司咪唑或特非那定合用也有發生心律失常的危險,故也應避免。
